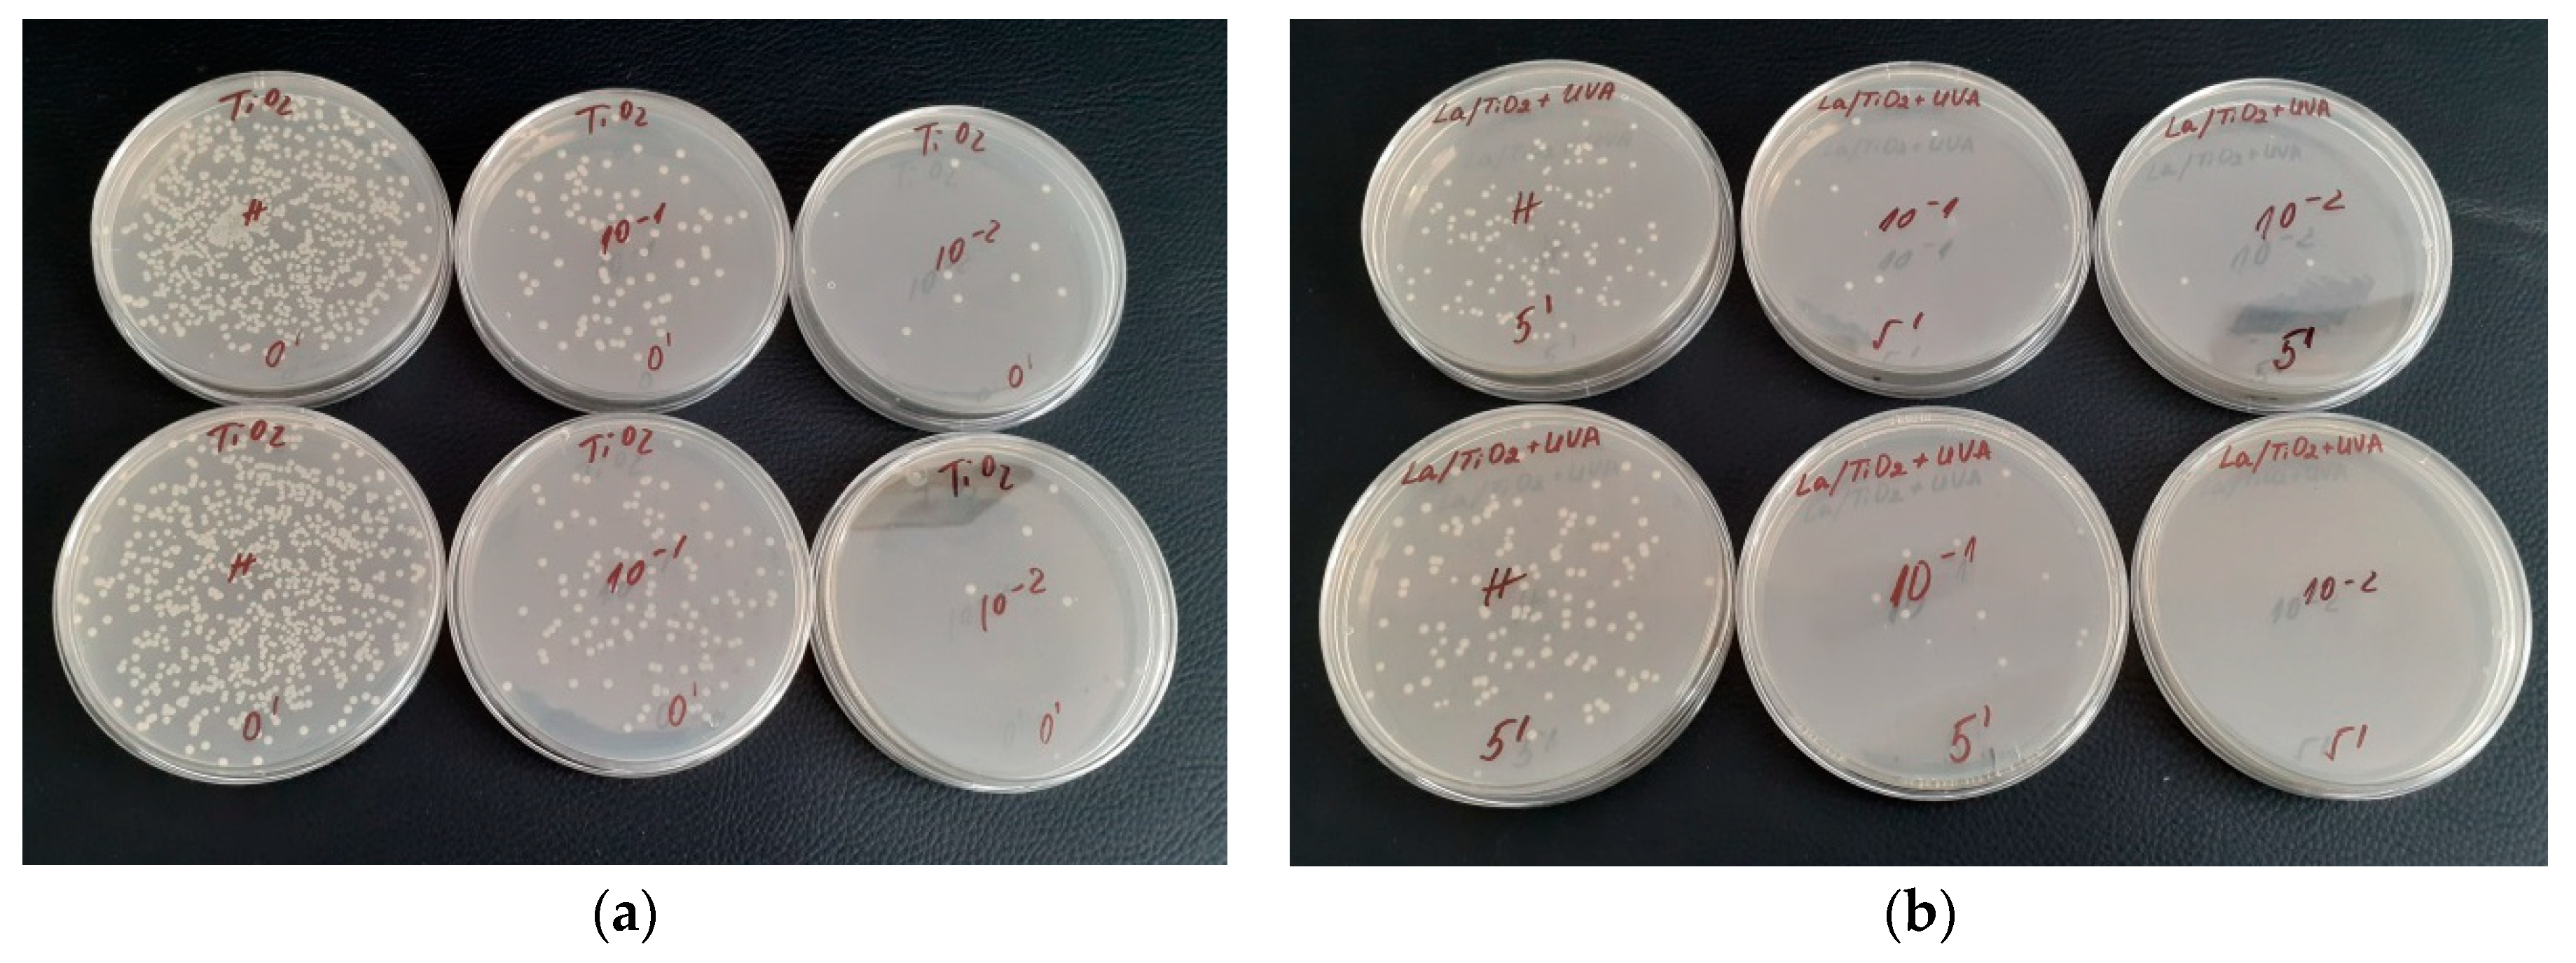
Catalysts 14 00469 g010
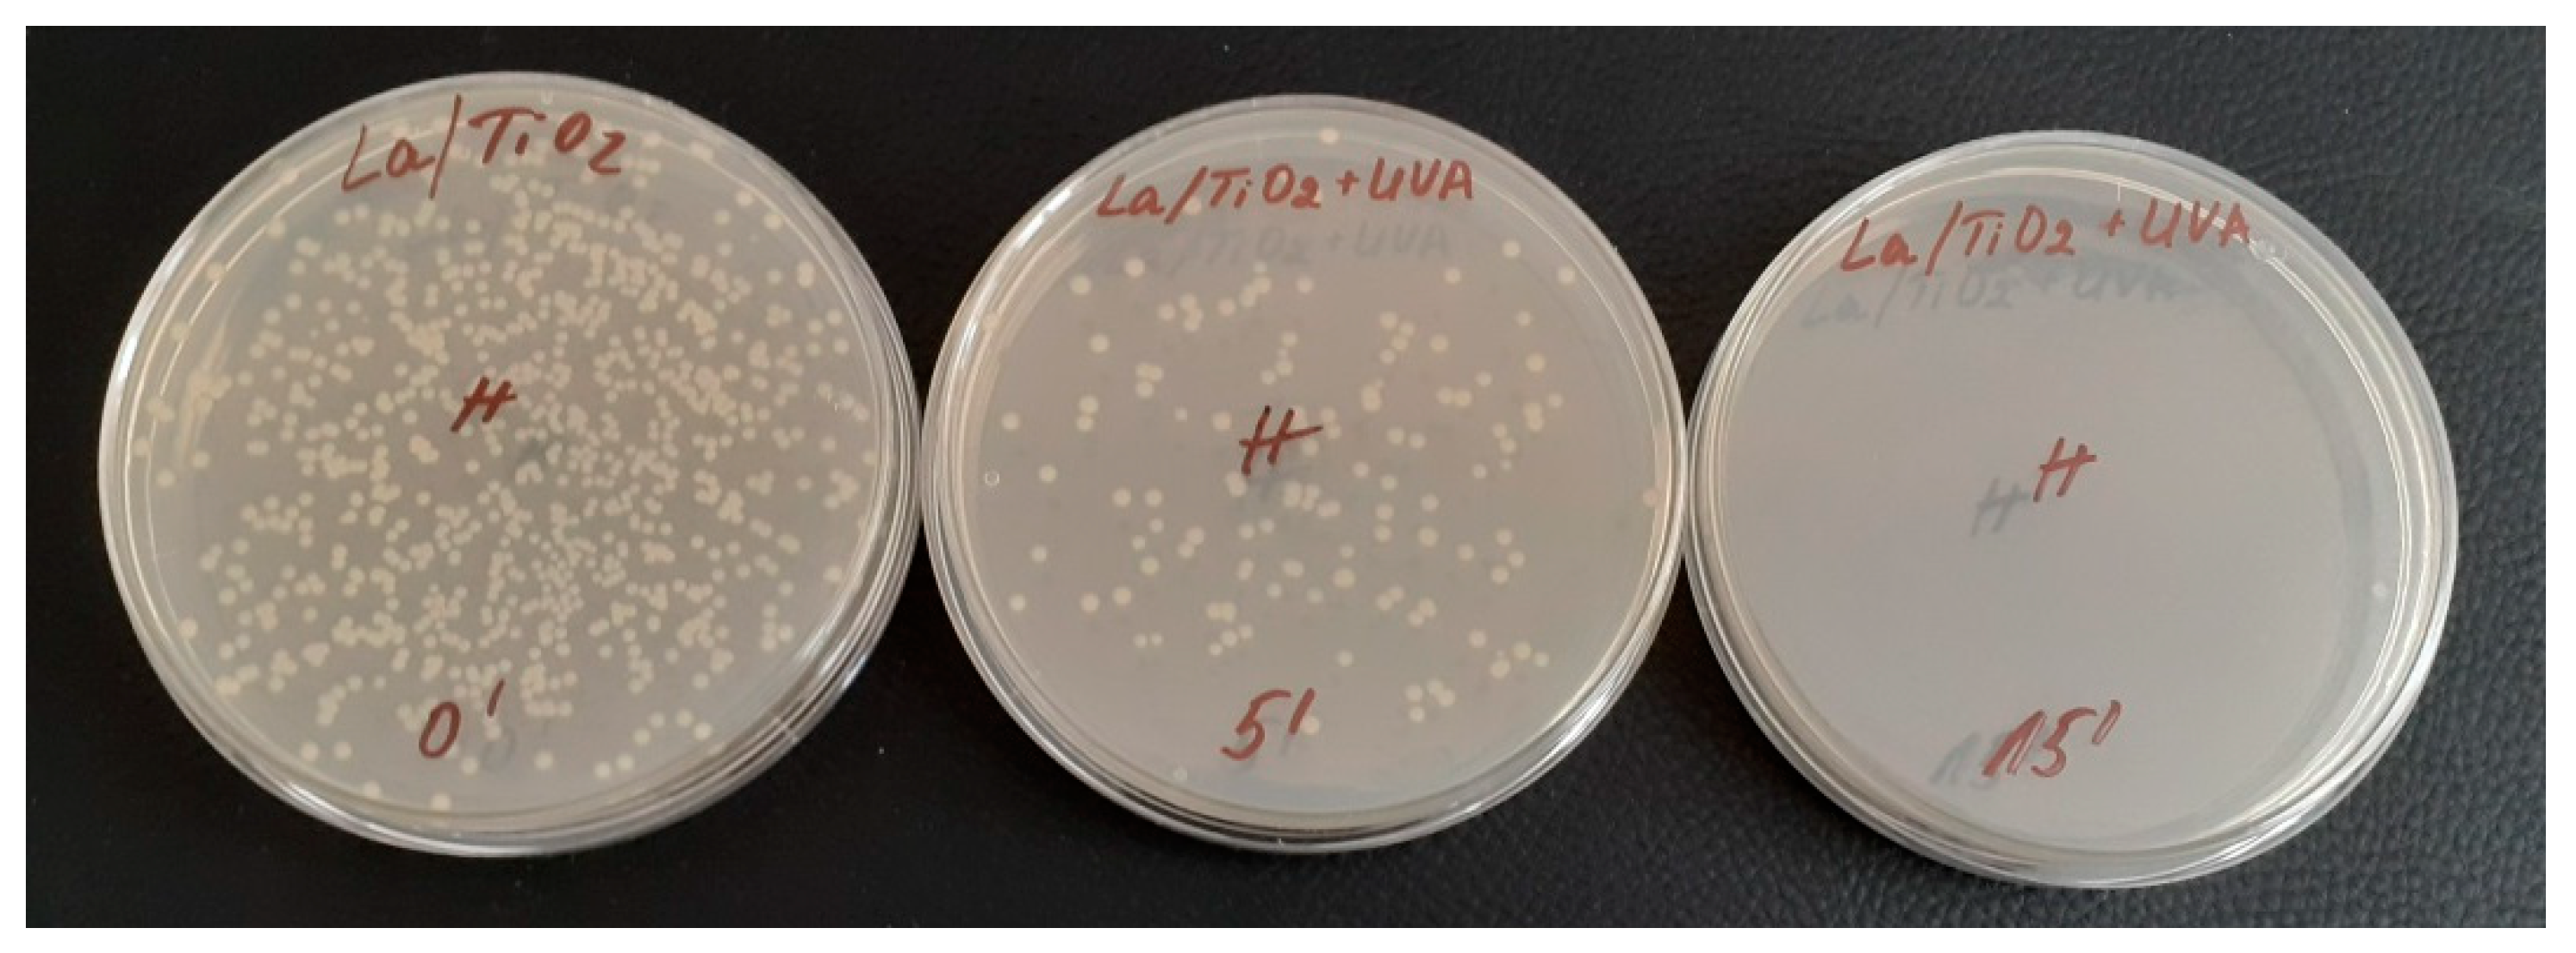
Catalysts 14 00469 g011

Photocatalytic Degradation of Paracetamol and Antibacterial Activity of La-Modified TiO2 Obtained by Non-Hydrolytic Sol–Gel Route
Abstract
1. Introduction
2. Results and Discussion
2.1. Phase Formation of Titania Samples
2.2. Transmission Electron Microscopy
2.3. IR and UV–Vis DRS Characterization
2.3.1. IR Structural Investigations
2.3.2. UV–Vis DRS Characterization
2.4. Photocatalytic Activity Experiments
2.5. Antibacterial Properties
3. Materials and Methods
3.1. Materials and Samples Preparation
3.2. Samples Characterization
3.2.1. Photocatalytic Experiments
3.2.2. Antibacterial Activity Measurements
4. Conclusions
Author Contributions
Funding
Data Availability Statement
Acknowledgments
Conflicts of Interest
References
- Ibhadon, A.O.; Fitzpatrick, P. Heterogeneous Photocatalysis: Recent Advances and Applications. Catalysts 2013, 3, 189–218. [Google Scholar] [CrossRef]
- Acharya, R.; Parida, K. A review on TiO2/g-C3N4 visible-light- responsive photocatalysts for sustainable energy generation and environmental remediation. J. Environ. Chem. Eng. 2020, 8, 103896. [Google Scholar] [CrossRef]
- Mishra, S.; Acharya, L.; Marandi, B.; Sanjay, K.; Acharya, R. Boosted photocatalytic accomplishment of 3D/2D hierarchical structured Bi4O5I2/g-C3N4 p-n type direct Z-scheme heterojunction towards synchronous elimination of Cr(VI) and tetracycline. Diam. Relat. Mater. 2024, 142, 110834. [Google Scholar] [CrossRef]
- Carp, O.; Huisman, C.L.; Reller, A. Photoinduced reactivity of titanium dioxide. Prog. Solid State Chem. 2004, 32, 33–177. [Google Scholar] [CrossRef]
- Ohtani, B. Photocatalysis A to Z—What we know and what we do not know in a scientific sense. J. Photochem. Photobiol. C Photochem. Rev. 2010, 11, 157–178. [Google Scholar] [CrossRef]
- Nakata, K.; Fujishima, A. TiO2 photocatalysis: Design and applications. J. Photochem. Photobiol. C Photochem. Rev. 2012, 13, 169–189. [Google Scholar] [CrossRef]
- Gupta, S.M.; Tripathi, M. A review of TiO2 nanoparticles. Chin. Sci. Bull. 2011, 56, 1639–1657. [Google Scholar] [CrossRef]
- Fujishima, A.; Zhang, X.; Tryk, D.A. TiO2 photocatalysis and related surface phenomena. Surf. Sci. Rep. 2008, 63, 515–582. [Google Scholar] [CrossRef]
- Fujishima, A.; Zhang, X. Titanium dioxide photocatalysis: Present situation and future approaches. Comptes Rendus Chim. 2006, 9, 750–760. [Google Scholar] [CrossRef]
- Bard, A.J.; Fox, M.A. Artificial Photosynthesis: Solar Splitting of Water to Hydrogen and Oxygen. Acc. Chem. Res. 1995, 28, 141–145. [Google Scholar] [CrossRef]
- Maeda, K. Photocatalytic water splitting using semiconductor particles: History and recent developments. J. Photochem. Photobiol. C Photochem. Rev. 2011, 12, 237–268. [Google Scholar] [CrossRef]
- Acharya, R.; Pani, P. Visible light susceptible doped TiO2 photocatalytic systems: An overview. Mater. Today Proc. 2022, 67, 1276–1282. [Google Scholar] [CrossRef]
- Akpan, U.G.; Hameed, B.H. The advancements in sol-gel method of doped-TiO2 photocatalysts. Appl. Catal. A Gen. 2010, 375, 1–11. [Google Scholar] [CrossRef]
- Khaki, M.R.D.; Shafeeyan, M.S.; Raman, A.A.A.; Daud, W.M.A. Application of doped photocatalysts for organic pollutant degradation—A review. J. Environ. Manag. 2017, 198, 78–94. [Google Scholar] [CrossRef] [PubMed]
- Jiang, D.; Otitoju, T.A.; Ouyang, Y.; Shoparwe, N.F.; Wang, S.; Zhang, A.; Li, S. A Review on Metal Ions Modified TiO2 for Photocatalytic Degradation of Organic Pollutants. Catalysts 2021, 11, 1039. [Google Scholar] [CrossRef]
- Han, F.; Kambala, V.S.R.; Srinivasan, M.; Rajarathnam, D.; Naidu, R. Tailored titanium dioxide photocatalysts for the degradation of organic dyes in wastewater treatment: A review. Appl. Catal. A Gen. 2009, 359, 25–40. [Google Scholar] [CrossRef]
- Nolan, N.T.; Synnott, D.W.; Seery, M.K.; Hinder, S.; Wassenhaven, A.V.; Pillai, S. Effect of N-doping on the photocatalytic activity of sol-gel TiO2. J. Hazard. Mater. 2012, 211–212, 88–94. [Google Scholar] [CrossRef] [PubMed]
- Abramovic, B.D.; Sojic, V.; Anderluh, N.; Abazovic, M. Nitrogen-doped TiO2 suspensions in photocatalytic degradation of mecoprop and (4-chloro-2-methylphenoxy) acetic acid herbicides using various light sources. Desalination 2009, 244, 293–302. [Google Scholar] [CrossRef]
- Piera, E.; Tejedor-Tejedor, M.I.; Zorn, M.E.; Anderson, M.A. Relationship concerning the nature and concentration of Fe(III) species on the surface of TiO2 particles and photocatalytic activity of the catalyst. Appl. Catal. B 2003, 46, 671–685. [Google Scholar] [CrossRef]
- Li, Z.; Shen, W.; He, W.; Zu, X. Effect of Fe-doped TiO2 nanoparticle derived from modified hydrothermal process on the photocatalytic degradation performance on methylene blue. J. Hazard. Mater. 2008, 155, 590–594. [Google Scholar] [CrossRef]
- Abazović, N.D.; Mirenghi, L.; Janković, I.A.; Bibić, N.; Šojić, D.V.; Abramović, B.F.; Čomor, M.I. Synthesis and Characterization of Rutile TiO2 Nanopowders Doped with Iron Ions. Nanoscale Res. Lett. 2009, 4, 518–525. [Google Scholar] [CrossRef] [PubMed]
- Rajput, P.; Deshpande, M.P.; Bhoi, H.R.; Chaki, S.H.; Pandya, S.J.; Mishra, M.; Sathe, V.; Das, S.; Tiwari, D.K.; Bhatt, S.V. Nanoarchitectonics of La-Doped Titanium Dioxide Nanoparticles for Optical and Antibacterial Properties. Nano 2022, 17, 2250104. [Google Scholar] [CrossRef]
- Anandan, S.; Vinu, A.; Lovely, K.L.P.S.; Gokulakrishnan, N.; Srinivasu, P.; Mori, T.; Murugesan, V.; Sivamurugan, V.; Ariga, A. Photocatalyticactivity of La-doped ZnO for the degradation of monocrotophos in aqueous suspension. J. Mol. Catal. A Chem. 2007, 266, 149–157. [Google Scholar] [CrossRef]
- Liu, H.; Yu, L.; Chen, W.; Li, Y. The Progress of TiO2 Nanocrystals Doped with Rare Earth Ions. J. Nanomater. 2012, 2012, 235879. [Google Scholar] [CrossRef]
- Marizcal-Barba, A.; Limón-Rocha, I.; Barrera, A.; Casillas, J.E.; González-Vargas, O.A.; Rico, J.L.; Martinez-Gómez, C.; Pérez-Larios, A. TiO2-La2O3 as Photocatalysts in the Degradation of Naproxen. Inorganics 2022, 10, 67. [Google Scholar] [CrossRef]
- Reszczynska, J.; Iwulska, A.; Sliwinski, G.; Zaleska, A. Characterization and Photocatalytic Activity of Rare Earth Metal-Doped Titanium Dioxide. Physicochem. Probl. Miner. Process. 2012, 48, 201–208. [Google Scholar]
- Weber, S.; Grady, A.M.; Koodali, R.T. Lanthanide modified semiconductor photocatalysts. Catal. Sci. Technol. 2012, 2, 683–693. [Google Scholar] [CrossRef]
- Golubović, A.; Tomić, N.; Finčur, N.; Abramović, B.; Veljković, I.; Zdravković, J.; Grujić-Brojčin, M.; Babić, B.; Stojadinović, B.; Šćepanović, M. Synthesis of pure and La-doped anatase nanopowders by sol–gel and hydrothermal methods and their efficiency in photocatalytic degradation of alprazolam. Ceram. Int. 2014, 40, 13409–13418. [Google Scholar] [CrossRef]
- Armaković, S.J.; Grujić-Brojčin, M.; Šćepanović, M.; Armaković, S.; Golubović, A.; Babić, B.; Abramović, B.F. Efficiency of La-doped TiO2 calcined at different temperatures in photocatalytic degradation of β-blockers. Arab. J. Chem. 2019, 12, 5355–5369. [Google Scholar] [CrossRef]
- Lee, H.; Park, J.; Lam, S.S.; Park, Y.-K.; Kim, S.-C.; Jung, S.-C. Diclofenac degradation properties of a La-doped visible light-responsive TiO2 photocatalyst. Sustain. Chem. Pharm. 2022, 25, 100564. [Google Scholar] [CrossRef]
- Viet, N.M.; Mai Huong, N.T.; Thu, H.P.T. Enhanced photocatalytic decomposition of phenol in wastewater by using La-TiO2 nanocomposite. Chemosphere 2023, 313, 137605. [Google Scholar] [CrossRef] [PubMed]
- Kayani, Z.N.; Rahim, S.; Sagheer, R.; Riaz, S.; Naseem, S. Assessment of antibacterial and optical features of sol-gel dip coated La doped TiO2 thin films. Mater. Chem. Phys. 2020, 250, 123217. [Google Scholar] [CrossRef]
- Li, Y.; Fang, C.; Zhuang, W.-Q.; Wang, H.; Wang, X. Antimicrobial enhancement via Cerium (II)/Lanthanum (III)-doped TiO2 for memergency leak sealing polyurea coating system. NPJ Mater. Degrad. 2022, 6, 41. [Google Scholar] [CrossRef]
- Thakur, N.; Thakur, N.; Kumar, A.; Thakur, V.K.; Kalia, S.; Arya, V.; Kumar, A.; Kumar, S.; Kyzas, G.Z. A critical review on the recent trends of photocatalytic, antibacterial, antioxidant and nanohybrid applications of anatase and rutile TiO2 nanoparticles. Sci. Total Environ. 2024, 914, 169815. [Google Scholar] [CrossRef] [PubMed]
- Malekshahi Byranvand, M.; Nemati Kharat, A.; Fatholahi, L.; Malekshahi Beiranvand, Z. A Review on Synthesis of Nano-TiO2 via Different Methods. J. Nanostructures 2013, 3, 1–9. [Google Scholar]
- Kim, D.S.; Kwak, S.Y. The hydrothermal synthesis of mesoporous TiO2 with high crystallinity, thermal stability, large surface area, and enhanced photocatalytic activity. Appl. Catal. A Gen. 2007, 323, 110–118. [Google Scholar] [CrossRef]
- Kim, C.-S.; Moon, B.K.; Park, J.-H.; Choi, B.-C.; Seo, H.-J. Solvothermal synthesis of nanocrystalline TiO2 in toluene with surfactant. J. Cryst. Growth 2003, 257, 309–315. [Google Scholar] [CrossRef]
- Otieno, O.V.; Csáki, E.; Kéri, O.; Simon, L.; Lukács, I.E.; Szécsényi, K.M.; Szilágyi, I.M. Synthesis of TiO2 nanofibers by electrospinning using water-soluble Ti-precursor. J. Therm. Anal. Calorim. 2020, 139, 57–66. [Google Scholar] [CrossRef]
- Jameel, M.H.; Hamzah, M.Q.; Bin Agam, M.A.; Alper, M. Synthesis and Characterizations of Co-Doped TiO2 Nanoparticles Via Co-Precipitation Method. Solid State Technol. 2020, 63, 267–277. [Google Scholar]
- Niederberger, M.; Pinna, N. Metal Oxide Nanoparticles in Organic Solvents; Springer: Berlin/Heidelberg, Germany, 2009. [Google Scholar]
- Debecker, D.P.; Mutin, P.H. Non-hydrolytic sol-gel routes to heterogeneous catalysts. Chem. Soc. Rev. 2012, 41, 3624–3650. [Google Scholar] [CrossRef]
- Stoyanova, A.; Sredkova, M.; Bachvarova-Nedelcheva, A.; Iordanova, R.; Dimitriev, Y.; Hitkova, H.; Iliev, T. Nonhydrolytic Sol-Gel Synthesis and Antibacterial Properties of Nanosized TiO2. Optoelectron. Adv. Mater.—Rapid Commun. 2010, 4, 2059–2063. [Google Scholar]
- Stoyanova, A.; Hitkova, H.; Ivanova, N.; Bachvarova-Nedelcheva, A.; Iordanova, R.; Sredkova, M. Photocatalytic and antibacterial activity of Fe-doped TiO2 nanoparticles prepared by nonhydrolytic sol-gel method. Bulg. Chem. Commun. 2013, 45, 497–504. [Google Scholar]
- Stoyanova, A.; Hitkova, H.; Bachvarova-Nedelcheva, A.; Iordanova, R.; Ivanova, N.; Sredkova, M. Synthesis and antibacterial activity of TiO2/ZnO nanocomposites prepared via nonhydrolytic route. J. Chem. Techn. Metall. 2013, 48, 154–161. [Google Scholar]
- Stoyanova, A.; Ivanova, N.; Bachvarova-Nedelcheva, A.; Iordanova, R. Synthesis and photocatalytic performance of Fe(III), N co-doped TiO2 nanoparticles. Bulg. Chem. Comm. 2015, 47, 330–335. [Google Scholar]
- Stoyanova, A.M.; Koleva, T.K.; Bachvarova-Nedelcheva, A.D.; Iordanova, R.S. Photocatalytic Bleaching of Two Organic Dyes Catalyzed by La-Doped Nanosized TiO2. Bulg. Chem. Comm. 2015, 47, 118–124. [Google Scholar]
- Stoyanova, A.; Bachvarova-Nedelcheva, A.; Iordanova, R. Photocatalytic degradation of two azo-dyes in single and binary mixture by La modified TiO2. J. Chem. Techn. Metall. 2018, 53, 1173–1178. [Google Scholar]
- Nešić, J.; Manojlović, D.D.; Anđelković, I.; Dojčinović, B.P.; Vulić, P.J.; Krstić, J.; Roglić, G.M. Preparation, characterization and photocatalytic activity of lanthanum and vanadium co-doped mesoporous TiO2 for azo-dye degradation. J. Mol. Catal. A Chem. 2013, 378, 67–75. [Google Scholar] [CrossRef]
- Peng, H.; Cui, J.; Zhan, H.J.; Zhang, X. Improved photodegradation and detoxifcation of 2,4,6-trichlorophenol by lanthanum doped magnetic TiO2. Chem. Eng. J. 2015, 264, 316–321. [Google Scholar] [CrossRef]
- Zhu, X.; Pei, L.; Zhu, R.; Jiao, Y.; Tang, R.; Feng, W. Preparation and characterization of Sn/La co-doped TiO2 nanomaterials and their phase transformation and photocatalytic activity. Sci. Rep. 2018, 8, 12387. [Google Scholar] [CrossRef]
- Bhange, P.D.; Awate, S.V.; Gholap, R.S.; Gokavi, G.S.; Bhange, D.S. Photocatalytic degradation of methylene blue on Sn-doped titania nanoparticles synthesized by solution combustion route. Mater. Res. Bull. 2016, 76, 264–272. [Google Scholar] [CrossRef]
- Ding, X.Z.; Liu, L.; Ma, X.M.; Qi, Z.Z.; He, Y.Z. Te influence of alumina dopant on the structural transformation of gel-derived nanometer titania powders. J. Mater. Sci. Lett. 1994, 13, 462–464. [Google Scholar] [CrossRef]
- Wang, Q.; Xu, S.; Shen, F. Preparation and characterization of TiO2 photocatalysts co doped with Iron (III) and lanthanum for the degradation of organic pollutants. Optoel. Adv. Mater.-RC 2011, 5, 128–134. [Google Scholar] [CrossRef]
- Zhang, X.; Zhou, G.; Zhang, H.; Wu, C.; Song, H. Characterization and activity of visible light–driven TiO2 photocatalysts co-doped with nitrogen and lanthanum. Transit Met. Chem 2011, 36, 217. [Google Scholar] [CrossRef]
- Murashkevich, N.; Lavitskaya, A.S.; Barannikova, T.I.; Zharskii, I.M. Infrared absorption spectra and structure of TiO2. J. Appl. Spectrosc. 2008, 75, 730–734. [Google Scholar] [CrossRef]
- Trujillano, R.; Rives, V.; García, I. Photocatalytic Degradation of Paracetamol in Aqueous Medium Using TiO2 Prepared by the Sol-Gel Method. Molecules 2022, 27, 2904. [Google Scholar] [CrossRef] [PubMed]
- Salehi, S.; Hosseinifard, M. Highly efficient removal of phosphate by lanthanum modified nanochitosan-hierarchical ZSM-5 zeolite nanocomposite: Characteristics and mechanism. Cellulose 2020, 27, 4637–4664. [Google Scholar] [CrossRef]
- Kočí, K.; Troppová, I.; Edelmannová, M.; Starostka, J.; Matějová, L.; Lang, J.; Čapek, L. Photocatalytic decomposition of methanol over La/TiO2 materials. Environ. Sci. Pollut. Res. 2017, 25, 34818–34825. [Google Scholar] [CrossRef] [PubMed]
- Parida, K.; Sahu, N. Visible light induced photocatalytic activity of rare earth titania nanocomposites. J. Mol. Cat. A Chem. 2008, 287, 151. [Google Scholar] [CrossRef]
- Huo, Y.; Zhu, J.; Li, J.; Li, G.; Li, H. An active La/TiO2 photocatalyst prepared by ultrasonication-assisted sol–gel method followed by treatment under supercritical conditions. J. Mol. Catal. A Chem. 2007, 278, 237–243. [Google Scholar] [CrossRef]
- Murzin, P.D.; Rudakova, A.V.; Emeline, A.V.; Bahnemann, D.W. Effect of the Heterovalent Doping of TiO2 with Sc3+ and Nb5+ on the Defect Distribution and Photocatalytic Activity. Catalysts 2022, 12, 484. [Google Scholar] [CrossRef]
- Li, F.; Li, X.; Hou, M. Photocatalytic degradation of 2-mercaptobenzothiazole in aqueous La3+-TiO2 suspension for odor control. Appl. Catal. B Environ. 2004, 48, 185. [Google Scholar] [CrossRef]
- Liu, Y.; Li, Z.; Green, M.; Just, M.; Li, Y.; Chen, X. Titanium dioxide nanomaterials for photocatalysis. J. Phys. Appl. Phys. 2017, 50, 193003. [Google Scholar] [CrossRef]
- Guo, Q.; Zhou, C.; Ma, Z.; Yang, X. Fundamentals of TiO2 photocatalysis: Concepts, mechanisms, and challenges. Adv. Mater. 2019, 31, 1901997. [Google Scholar] [CrossRef] [PubMed]
- Li, Q.; Wang, L.; Fang, X.; Zhang, L.; Li, J.; Xie, H. Synergistic effect of photocatalytic degradation of hexabromocyclododecane in water by UV/TiO2/persulfate. Catalysts 2019, 9, 189. [Google Scholar] [CrossRef]
- Quan, X.; Zhao, Q.; Tan, H.; Sang, X.; Wang, F.; Dai, Y. Comparative study of lanthanide oxide doped titanium dioxide photocatalysts prepared by coprecipitation and sol–gel process. Mat. Chem. Phys. 2009, 114, 90–98. [Google Scholar] [CrossRef]
- Ökte, A. Characterization and photocatalytic activity of Ln (La, Eu, Gd, Dy and Ho) loaded ZnO nanocatalysts. Appl. Catal. A Cen. 2014, 475, 27–39. [Google Scholar] [CrossRef]
- Chaker, H.; Ameur, N.; Saidi-Bendahou, K.; Djennas, M.; Fourmentin, S. Modeling and Box-Behnken design optimization of photocatalytic parameters for efficient removal of dye by lanthanum-doped mesoporous TiO2. J. Environ. Chem. Eng. 2021, 9, 104584. [Google Scholar] [CrossRef]
- Zhu, L.; Xiao, Y.; Wang, X. The Photocatalytic Oxidation Properties of La3+-doped and Ce4+-doped ZnO-TiO2 in Treating Pharmaceutical Wastewater. Adv. Mater. Res. 2013, 726–773, 2988–2992. [Google Scholar] [CrossRef]
- Ilkhechi, N.; Akbarpour, N.; Yavari, M.R.; Azar, Z. Sn4+ and La3+ co doped TiO2 nanoparticles and their optical, photocatalytic and antibacterial properties under visible light. J. Mater. Sci. Mater. Electron. 2017, 28, 16658–16664. [Google Scholar] [CrossRef]

| Sample | Map Sum Spectrum | wt % | at % |
|---|---|---|---|
| 1 La/TiO2 | O | 25.50 | 51.02 |
| Ti | 72.64 | 48.55 | |
| La | 1.85 | 0.43 |
| Sample | Cut-Off, nm | Eg, eV |
|---|---|---|
| undoped TiO2 | 388.33 | 3.19 |
| 0.4% La-TiO2 | 368.61 | 3.36 |
| 1% La-TiO2 | 364.87 | 3.39 |
| 5% La-TiO2 | 369.67 | 3.35 |
Disclaimer/Publisher’s Note: The statements, opinions and data contained in all publications are solely those of the individual author(s) and contributor(s) and not of MDPI and/or the editor(s). MDPI and/or the editor(s) disclaim responsibility for any injury to people or property resulting from any ideas, methods, instructions or products referred to in the content. |
© 2024 by the authors. Licensee MDPI, Basel, Switzerland. This article is an open access article distributed under the terms and conditions of the Creative Commons Attribution (CC BY) license (https://creativecommons.org/licenses/by/4.0/).
Share and Cite
Stoyanova, A.; Hitkova, H.; Kaneva, N.; Bachvarova-Nedelcheva, A.; Iordanova, R.; Marinovska, P. Photocatalytic Degradation of Paracetamol and Antibacterial Activity of La-Modified TiO2 Obtained by Non-Hydrolytic Sol–Gel Route. Catalysts 2024, 14, 469. https://doi.org/10.3390/catal14080469
Stoyanova A, Hitkova H, Kaneva N, Bachvarova-Nedelcheva A, Iordanova R, Marinovska P. Photocatalytic Degradation of Paracetamol and Antibacterial Activity of La-Modified TiO2 Obtained by Non-Hydrolytic Sol–Gel Route. Catalysts. 2024; 14(8):469. https://doi.org/10.3390/catal14080469
Chicago/Turabian StyleStoyanova, Angelina, Hristina Hitkova, Nina Kaneva, Albena Bachvarova-Nedelcheva, Reni Iordanova, and Polya Marinovska. 2024. "Photocatalytic Degradation of Paracetamol and Antibacterial Activity of La-Modified TiO2 Obtained by Non-Hydrolytic Sol–Gel Route" Catalysts 14, no. 8: 469. https://doi.org/10.3390/catal14080469
APA StyleStoyanova, A., Hitkova, H., Kaneva, N., Bachvarova-Nedelcheva, A., Iordanova, R., & Marinovska, P. (2024). Photocatalytic Degradation of Paracetamol and Antibacterial Activity of La-Modified TiO2 Obtained by Non-Hydrolytic Sol–Gel Route. Catalysts, 14(8), 469. https://doi.org/10.3390/catal14080469

